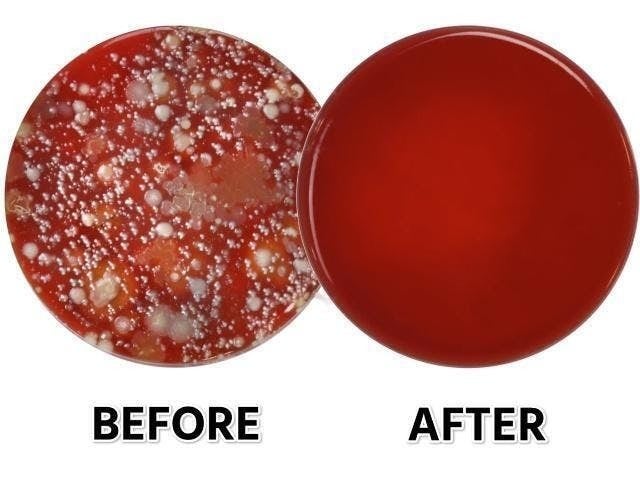

あなたは自分の手を洗っていますか?
最近はとくにしっかり洗っているという方も多いかもしれません。
では、あなたが手を洗う直前まで触っていたスマホは洗っていますか?
現在、世界規模で除菌に対するニーズが高まっています。
こんな社会情勢の中、輸入商社である私たちも何か社会の役に立ちたい。そんな想いから、
アメリカで100万台の出荷実績を誇るスマホ専用除菌装置「PHONESOAP」を特別価格で提供するキャンペーンを実施することにしました。
令和の新習慣「スマホ洗い」を広める私たちの仲間になりませんか?


PHONESOAP(フォンソープ)は、UV-Cという特殊な紫外線で、
あなたのスマホを10分で99.9%除菌できる装置です。
本国アメリカでは、Discovery Channel、Shark Tank(アメリカ版マネーの虎)など、数多くのメディアで取り上げられている次世代のプロダクトです。
日本でも、ギズモードジャパン、ライブドアニュース、エキサイトニュース、雑誌「Begin」など、数多くのメディアに取り上げられ、今最も注目されているガジェットです。

あなたが一日中触っているスマートフォン。
スマホを洗わないのは、もはや手を洗わないのと同じです。
PHONESOAPで「手を洗わない生活」を卒業しましょう!

あなたはもしかして、職場や自宅のトイレでスマホをいじっていませんか?
もしそうだとしたら、あなたに大変残念なお知らせがあります。
それは、、

あなたが今触っているスマホは、便器の18倍の細菌が付いているかもしれない
ということです。
米国ダコタ大学での調査によると、スマートフォンの表面に付着した菌の数は、公衆トイレの18倍多いという結果が出ました。
https://www.kxnet.com/news/nursing-students-study-cell-phones-and-bacteria/

・トイレでついスマホを使ってメールチェックしてしまう方
・満員電車の吊り革を触ったあとでスマホでニュースを見てしまう方
・食材を触ったあとでスマホでレシピサイトを見てしまう方
手に付いた汚れは全てあなたのスマホについています。

トイレに行ったあとで、手は洗いますよね。では、トイレで触ったスマホは洗いましたか?

これは言ってしまえば、一度も洗ったことがない「手」があるのと同じです。
そんな洗ったことがないスマホを知らないうちに子供が触ったり、口に入れたりしていたら、、
ちょっと心配ですよね。

子供はスマホが大好きなので、あなたが目を離している間にあなたが思っている以上に触っているかもしれませんよ。

そもそも、なぜスマホはそんなに汚れてしまうのでしょうか?
トイレで使うほかにも、ほかの人との握手する、お金を触る、電車の吊り革をにぎる、ジムで誰かが汗だくの手で握ったバーベルを握る、肉や魚を切りながらレシピを検索する、他人のスマホを触るなど、私たちの手は様々なシチュエーションで汚れにさらされています。

そして、その汚れの付いた手でスマホの表面をタップしたり、スワイプしたりしています。
スマホは汚れて当然なのです 。


アメリカのある調査会社によると、人はタップやスワイプなど、一日トータルで2617回スマホにタッチしているそうです。
右利きの人は、自分の左手に触る回数よりもスマホに触る回数のほうが多いのです。
スマホにはもはや、第三の手と言っても過言ではありません。
これまで手を洗ったことがないという人はほとんどいないでしょう。でも、スマホは洗ったことがない人のほうが多いのではないでしょうか?
スマホを洗わないのは、手を洗わないのと同じです。
フォンソープで「手を洗わない生活」を卒業しましょう!

フォンソープでスマホを除菌するのはとっても簡単です。
スマホを中に入れて、フタを閉じればあとは勝手に除菌ができます。
あとは10分待つだけで、99.9%除菌完了!


本体裏側にUSBポートとUSB-Cポートがあります。
ここにスマホ充電用のケーブル(iPhoneの場合はライトニングケーブル、Androidの場合はUSBケーブル)を挿すとここからスマホに給電できます。
また、本体のフタにはケーブルを通すための穴があいています。
この穴を通せば、除菌しながら充電が可能です。

UV-Cはたしかに除菌効果が最も高い紫外線と言われています。一方で、直接人体に照射してしまった場合の人体への悪影響が指摘されています。
従来のような、UV-Cが目に入る可能性がある開放型の除菌装置では、操作ミス、子供のいたずらなどが心配です。

フォンソープは、フタを閉じたらスイッチON、フタを開けたら勝手にスイッチOFFされるので、UV-Cが目に入る心配がありません。
小さいお子さんがいる家庭でも安心です。

フォンソープには、UV-Cライトが本体内部の上下に2個ついています。
これにより、スマホをひっくり返したりすることなく、簡単に、一度でムラなく紫外線を照射することができます。


フォンソープは、現在流通しているほぼ全てのスマートフォンに使用することができます。
iPhoneXS MAXのような大型のスマホでも、使用することが可能です。
ただし、ZenFone 3 UltraやXperia Z Ultraなどの超大型スマホの場合は入らないものもあります。
スマートフォン収納部分173 X 95 X 20 mm
念のため、あなたのスマートフォンのサイズを確認してくださいね。


壁コンセントにACアダプタを挿して、フォンソープ本体を電源につなぎます。

スマホを入れてフタを閉じれば除菌ランプが青く光り、自動で除菌開始します。

10分後、青い除菌ランプが消えたら除菌完了です。


夜寝る前に、スマホをフォンソープにセットしておけば、自動で除菌して、終わったら停止します。
朝には除菌されたスマホを使うことができます。

フタを開ければUVライトが止まるので、もし小さいお子さんと同じ部屋で寝ていても安心です。
中の音が聴こえる設計になっているので、もしスマホを中に入れているときに着信やアラームが鳴ったとしても、すぐに気づくことができます。


オフィスにフォンソープが一台あれば、同僚もみんなでスマホがキレイ。
オフィスを訪問したお客様との話題作りにも最適です!


フォンソープはスマホ以外にも使えます。
例えば、スマートウォッチ、イヤフォン、お金、クレジットカード、カギなど、サイズが合うものなら何でも除菌することができます。


3つのカラーバリエーションを準備しました。
インテリアや好みに合わせてお選び下さい。


高い除菌効果が得られる秘密は、UV-Cという特殊な波長の紫外線にあります。
UV-Cは波長100nmから280nmというごく短い波長の光のことです。
UV-Cは太陽光にも含まれていますが、オゾン層と大気で吸収、散乱されてほとんど地表に届くことはありません。

最も除菌効果の高い紫外線の波長は、250nmから260nmという研究結果があります。
(出展:照明学会照明普及編照明教室No.62)
フォンソープは、この除菌効果の高い波長の紫外線を発生させるため、高い除菌効果を得ることができます。

図の出展:気象庁HP「紫外線とは」

アメリカの検査機関であるRichard Industrial Microbiology Laboratoryで除菌効果は実証実験済みです。

試験方法は、スマホのダミー、クレジットカード、カギのモデルを準備し、ダミーに4種類の菌を付着させます。その後フォンソープで除菌したスマホダミーの10箇所と、クレジットカード、カギで何%の菌が除菌できたかを検証しています。
この結果、全ての実験箇所で99.9%除菌効果があったことが確認されています。

私はフォンソープをキッチン、ジムなど色々な場所で使っています。動物関係の仕事をしているので細菌は気になっていましたが、PhoneSoapを利用してから顔にスマホを当てても平気です。

本当に簡単で、数分で完了!もう大好きです!鍵やお金もきれいにしました。もう一つ買って子供のクリスマスプレゼントにする予定です。

仕事中、私はいつも人と会い、握手し、細菌を拡散させ、そして私の電話に触れています。
フォンソープに出会えて本当にうれしいです。USBポートもあり充電できるのもとても良いです。

赤ちゃんが私の電話をつかんで、口の中にそれを詰め込もうとしているのを見つけたとしても安心です。

家族で使えます。簡単で短い時間で除菌できるからです。
私の携帯で使ったあと、次は家族のスマホを入れて、それですべて完了です!
私はこの商品を強くおすすめします!

フォンソープは海外製品ですが、日本の安全基準に準拠しています。
代理店であるGraspy International株式会社は製造物責任保険にも加入しており、万が一何らかの事故が起きた場合にも安心です。


1年間の製品保証をお付けします。
クラウドファンディングだからといって、商品を届けたらおしまい、アフターフォローはしないなんてことはしたくありません。
弊社では、責任を持ってお届けするのはもちろん、お届け後にも安心して使って頂けるようしっかりとサポートいたします。
お届け後1年以内に発生した自然故障について、新しい商品と交換させて頂きます。
ただし、落下、水濡れなど自然故障以外の場合には保証の対象とはなりませんのでご注意下さい。

Q 手帳型スマホケースを使っていても使えますか?
A お使いいただけます。ただし、除菌効果を十分得るためには、ケースを閉じた状態とケースを開いた状態の2回行うことをおすすめします。
Q どんな大きさのスマホにも使えますか?
A iPhone XS MaxやiPhone 8 Plusなど、大型のスマホでもほとんどのスマホにお使いいただけます。ただし、Zenfone Ultraシリーズなど、超大型のスマホではお使いいただけない場合があります。
Q フォンソープはスマホやケースにダメージを与えませんか?
A フォンソープはUV-C照射開始から10分で自動的に照射が終了します。
このような短時間では、スマホに対して悪影響はありません。
Q タブレットには使えますか?
A サイズが大きいため、お使い頂くことができません。
Q フォンソープは医療機器として使えますか?
A フォンソープは医療機器ではありません。全ての菌を完全に除去したり、特定の疾病を予防するものではありません。

フォンソープのストーリーは、2009年に2人のアメリカ人WesとDanが、アメリカの名門ブリガムヤング大学で出会うところから始まりました。

Wes はライフサイエンスを専攻し、Danはマーケティングを専攻する普通の学生でした。
この頃、彼らはテレビのドキュメンタリーで、携帯電話の多くが糞便由来の汚れに汚染されていることを知り、衝撃を受けました。
この体験が、フォンソープの開発開始につながることになったのです。
Wesのライフサイエンスの知識とDanのマーケティングの知識を組み合わせてフォンソープの事業構想を練りました。
その結果、彼らはスチューデンツイノベーターオブザイヤーをはじめ多くの賞を受賞しました。
それと同時に、彼らはフォンソープのプロトタイプの設計に取り組みました。

2012年、彼らはアメリカのクラウドファンディングサイト「Kickstarter」にて、フォンソープの出資を募りました。その結果、彼らは目標としていた18,000ドルの3.5倍にあたる63,000ドルを調達することに成功しました。
翌年には、中国で初めて量産型のフォンソープを生産しました。このときに量産されたのはフォンソープの初号機であるバージョン1.0と呼ばれるものでした。
2014年に初めてフォンソープが一般販売開始されました。また、社会的な注目度の高さから、Shark Tank、Discovery Channelなど多くのメディアに取り上げられ、人気プロダクトとなりました。
その後、プロダクトの改良が繰り返され、今回ご紹介するバージョン3.0が完成しました。バージョン3.0は最初の量産モデルである1.0に比べると、比較にならないほど完成度が高まっています。
現在も、継続的にプロダクトの改良が繰り返されています。フォンソープは今も進化しているのです。

並行輸入品が発生する可能性があります。個人輸入及び販路によっては防ぐことができない可能性がある点、ご了承願います。
ただし、並行輸入品として出回る商品はほぼ全て電気用品安全法に違反した違法商品です。
出どころ不明の並行輸入品は保証も受けることができないため、ご注意ください。

このページを最後まで見てくれたあなたへ。
あなたは、あまりキレイじゃないと分かっていながらも、トイレでスマホを使ってメールをチェックしてしまったり、料理しながらついレシピをスマホで確認したりしてしまっていませんか?
正直に白状すると、恥ずかしながら私はどちらもやってしまいます。
私には7歳と3歳の子供がいます。
子供たちはLINE通話で祖父母とビデオ通話したり、Youtubeで子供向けの動画を見たり、私のスマホを使うのが大好きです。
正直、私は「除菌」に対してそれほど積極的なほうではありません。
ですが、私のスマホを使う子供たちの姿を見るとき、自分のスマホは本当にきれいなのか、子供たちにさわらせて大丈夫なのかと、後ろめたいような気持ちをずっと感じていました。

アルコール入のティッシュなども試しましたが、ボタンやスピーカーの部分は拭いていいのか、表面のコーティングは剥がれないのか、色々と心配でやめてしまいました。
スマホをきれいにする方法について調べていると、海外で100万台の出荷実績を持つフォンソープと出会いました。
早速海外からサンプルを取り寄せ、使ってみました。
菌は見た目には見えないのでスマホに見た目の変化はありませんが、これで子供たちにスマホを渡すときに後ろめたい気持ちを感じなくて済むという、なんともいえない安心感を感じることができました。
スマホの除菌グッズは、2018年に有吉ゼミというTV番組で紹介されるなど、各種メディアでも注目され、やはり多くの人がスマホをきれいにすることを望んでいることを確信しました。
自分と同じように、スマホの汚れに悩んでいる方のために、ぜひフォンソープを日本で広めたいという思いで今回のプロジェクトを立ち上げました。
単にこの商品を普及させるというだけでなく、日本で「手洗い」と同じように「スマホ洗い」の文化を定着させたいと思っています。
ぜひとも、まずは一度フォンソープを使ってみていただきたいと思います。
今回のプロジェクトのために、日本の電気用品安全法等の規制もクリアしています!
また弊社は製造物責任保険にも加入しております。万が一の事故にもしっかりと対応させて頂きますので、ご安心下さい。
「スマホ洗い」文化を広める私たちの仲間になりませんか?
みなさまのご支援をお待ちしています!
■特定商取引法に関する記載
◯ 販売事業者名: Graspy International 株式会社
◯ 事業者の所在地:大阪府大阪市中央区南船場4丁目10番5号
◯ 事業者の連絡先:メール: infoあっとgraspy.net (あっとを記号にしてください)
※こちらでは当該製品に対するお申し込み、質問等は受け付けておりません。
◯ リターン価格:各リターン記載の通り
※ 商品内容に関してはリターン欄記載の通り
※ リターン価格とは別にcampfire(machi-ya)のシステム利用料として1支援毎に200円(税別)が支援者様の負担となります。尚、このシステム利用料はcampfireが受け取るもので、当社が受領するものではございません。
◯ 申込期限:当ページ記載のプロジェクト終了期限通り
◯ 支払い方法:クレジットカード払い(Visa/Mastercard/JCB/Diners Club/American Express)/コンビニ払い(全国の主要コンビニエンスストア)/銀行振込(銀行ATM・ネットバンキング)/auかんたん決済/ソフトバンクまとめて支払い・ワイモバイルまとめて支払い/ドコモ払い
◯ 支払い時期 :当プロジェクトは「All-in型」の為、目標達成の如何に問わず、ご契約が成立しリターンをお届けします。その為、お申込みと同時にご利用の決済方法に準じてご請求となります。
◯ 引渡し時期: 各リターン詳細に記載の発送予定月を引き渡し時期とします。但し、開発・生産状況によって遅れが生じる場合がありますのでその際は当プロジェクトページ内の「活動報告」または購入者へのメール等で連絡します。
◯ キャンセル・返品: 当プロジェクトは「All-in型」の為、お申込み完了をもって契約が成立いたします。その為、お客様都合による返品・キャンセルはできませんのでご注意ください。尚、製品到着後に破損や初期不良がある場合には交換させていただきますので「メッセージで意見や問い合わせを送る」から、または納品書記載の連絡先までお問い合わせください。
※上記以外の事項に関しては、お取引の際に請求があれば遅延なく提示いたします。
最新の活動報告
もっと見る7月配送分の発送について
2020/06/05 14:39支援者のみなさま暑くなってきましたが、お元気にされていますか?○ホワイトをご支援頂いたみなさま先日の活動報告で7月配送予定分も前倒しで5月に発送できそうだとお伝えしておりました。しかし、ホワイトのみ入荷数が予定より若干少なく、ホワイトのみ出荷は6月の中旬~下旬に出荷させて頂きたいと思っております。予定より早く入手できることを楽しみにしていただいていたのに申し訳ありません。○ホワイト以外の色をご支援頂いたみなさま先週出荷の予定でしたが、少し遅れております。来週明けには出荷できる予定ですので、もうしばらくお待ちください。なるべく早く全てのみなさまにお届けできるように全力を尽くしますので、もうしばらくお待ちください。よろしくお願いいたします。 もっと見る5月29日に全ての支援者のみなさまへの配送を完了しました!
2020/05/31 18:005月29日に全ての支援者のみなさまへの配送を完了しました!新型コロナの流行により物流がなかなか動かず厳しい状況ではありましたが、なんとかお約束した5月の配送に間に合わせることができました。また、手持ちの在庫がなんとか足りましたので7月に配送予定だったみなさまにも、前倒しで配送することができました。万が一配送したPHONESOAPに不具合が発生した場合には、保証対応させて頂きますのでご安心下さいね。PHONESOAPの最新情報はInstagramで発信しております。ぜひフォローと、使ってみた感想を#phonesoapjp を付けてシェアして頂ければ大変うれしく思います。https://www.instagram.com/phonesoap_jp/ぜひPHONESOAPを毎日活用して頂き、令和の新習慣「スマホ洗い」を広める仲間になって頂ければ非常に嬉しく思います。ご支援まことにありがとうございました。 もっと見る出荷を開始いたしました!
2020/05/29 08:30PHONESOAPをご支援いただいたみなさま昨日、5月28日に大阪の弊社契約倉庫から出荷を開始いたしました。昨今の情勢で物流が滞っている状況ではありましたが、なんとかお約束した5月中にみなさまにPHONESOAPをお届けできる予定です!みなさま楽しみにお待ちください。ご不明点あればいつでもご連絡下さいね。引き続きよろしくお願いいたします。 もっと見る





メールをいただきありがとうございます。 ランプは固定式で取り外しは出来ません。 1年くらいでは壊れないですが、1年間の製品保証を付けております。 この範囲内でランプが切れたら交換させていただきます。
内蔵の紫外線ランプが切れた場合、交換ランプは市販されていて容易に入手できるのでしょうか。そうであれば、具体的な製品名と値段を教えてください。